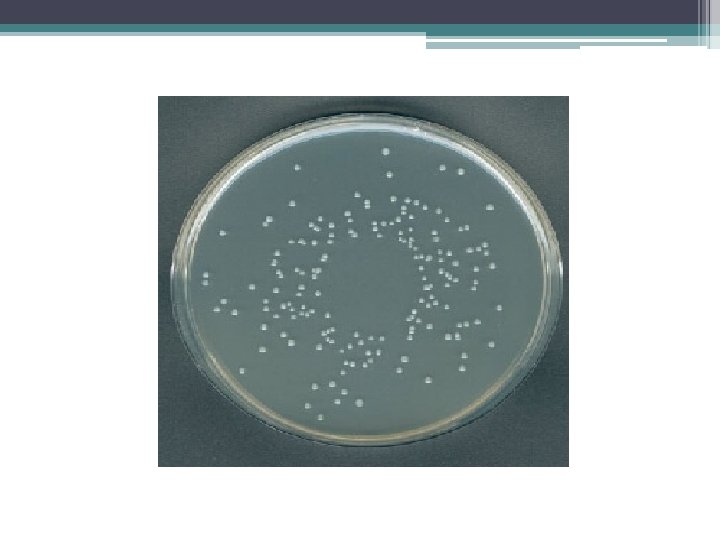

Bacterial count Total bacterial count It determines the

Bacterial count

Total bacterial count • It determines the No. of both living and dead bacteria. • Such as: 1 - Nephelometric method 2 - Counting chamber method

Nephelometric method Turbidity: Bacterial growth makes solution “turbid”. Particulate objects such as bacteria will scatter light, The amount of scattering is proportional to cells number. Use Nephlometer to determine the amount of light scattered by a suspension of cells.


Counting Chamber method

Viable bacterial count It determines the No. of living bacteria only. • The common methods: 1 - Pour plate method 2 - Spread ( surface) method 3 - Miles and Misra method

Pour plate method Dilution: Because of the huge number of bacterial colonies and their small size, counting the number of bacteria in a sample can be difficult. bacterial samples must be diluted considerably to obtain reasonable counts.

For nearly all environmental samples, a dilution step is needed: • e. g. 1 ml of surface water contains 106 cells/ml spread 1 ml per plate: 1, 000 colonies too high, would fill surface. 0. 1 ml per plate= 1, 000 colonies countable 0. 001 ml per plate= 100 colonies countable, but volume too small to measure accurately

Serial Dilutions of the Sample • If we take one ml of the original sample and add it to 9 ml of sterile water, it will give 1: 10 or 10 -1 dilution of original sample, i. e. the original sample has been diluted to 1/10 th. Similarly we may prepare 1: 100 (10 -2), 1: 1, 000 (10 -3), 1: 10, 000 (10 -4) and so on dilutions of the original sample.


Principle of pour plate method • The sample should be diluted successively with sterile water. The agar medium is maintained in molten state at 45° c. • One ml of each dilution (-5, -6, -7) is added to each sterile an empty labeled Petri dish, Then pour 9 ml molten agar (45°c) into above Petri dish. • The contents are thoroughly mixed, and allowed to solidify. The dishes are incubated at suitable temperature 37 c. • After few days 24 -48 hrs , different kinds of microbes grow as separate colonies. Colonies are counted.

Pour plate method Advantages : • Does not require previously poured plates • Less work, less risk of contamination • Anaerobes and facultative anaerobes grow within the agar Disadvantages : • Heating could kill some organisms • Oxygen diffusion is not sufficient for obligate aerobes

Spread method Spread plating method • Place (0. 1 ml) of each dilution(-5, -6, -7) onto solid agar. • Spread with sterile glass or metal spreader. • Incubate (minimum 24 hrs, usually 48 hrs) • Colonies are counted

Miles and Misra • Divide plate into 3 sections -5, -6, -7. • To each section , deliver 1 drop of the corresponding dilution using Pasteur pipette. Do not throw the pipette after finishing, calculate using 1 ml of water, how many drops are delivered of 1 ml water. • Incubate the plate at 37 c for 24 hrs. # Colony forming units (CFU) = count of bacteria

-5 -6 -7

Calculation of Bacterial count • The aim is to calculate how many colony forming units (C. F. U. ) of organism which present in the original sample. • X = N/D X = number of bacteria N = number of colonies counted on a plate D = dilution factor (either 1, 10 or 100)

Calculation of pour plate method: 100 colonies X in 1 ml of 10 -6 dilution in 1 ml of original sample X (no of bacteria in original sample) X = 100 x 1/ 1 x 10 -6 = 100 x 106 C. F. U/ ml = 1 x 108 C. F. U/ml

Calculation of spread plate method 50 colonies X in 0. 1 ml of 10 -6 dilution in 1 ml of original sample x (no of bacteria in original sample) x = 50 x 1/ 1 x 0. 1 x 10 -6 = 50 x 106 C. F. U/ ml = 5 x 108 C. F. U/ml

Calculation of miles and misra plate method 5 colonies X in a drop of 10 -6 dilution in 1 ml of original sample Note: 1 ml of Pasteur pipette= 40 drops x (no of bacteria in original sample) x= 5 x 40/ 1 x 10 -6 = 200 x 106 C. F. U/ ml = 2 x 108 C. F. U/ml
- Slides: 20